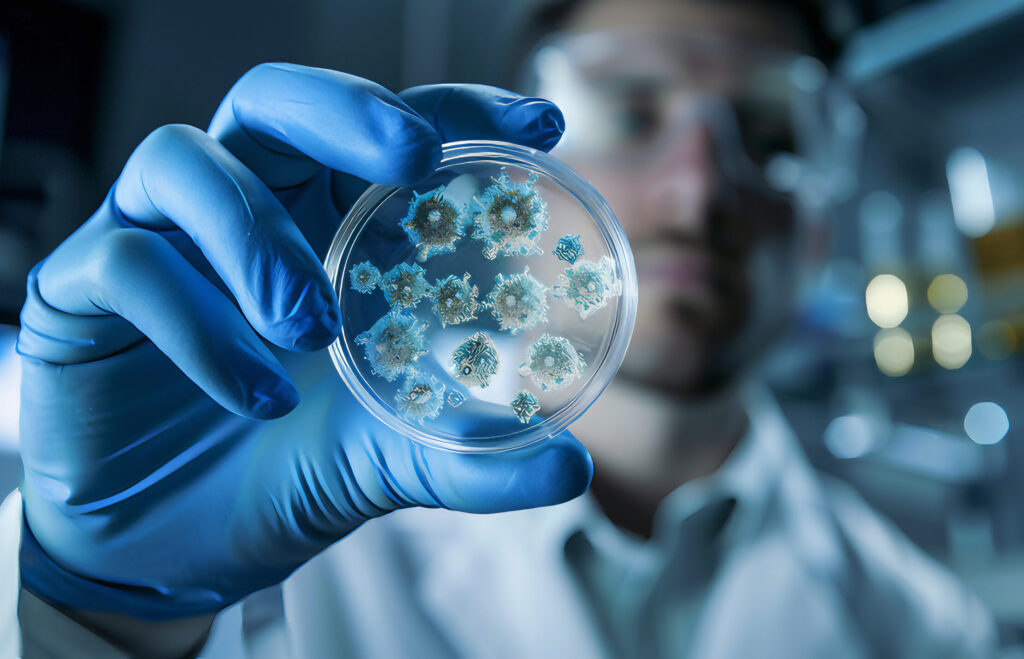

Tatort Biofilm: Unsichtbare Pilze werden durch Resistenzen zur tödlichen Gefahr
Pilze gehören zur natürlichen Umwelt. Ihre Sporen schweben ständig in der Luft, setzen sich auf Oberflächen ab oder gelangen über Schuhe, Kleidung und Staub in Innenräume. Meist ist das harmlos – doch einige Pilzarten haben in den vergangenen Jahren weltweit für Aufsehen gesorgt. Sie sind kaum sichtbar, können aber schwere Infektionen auslösen und weisen teils weitreichende Resistenzen gegen gängige Medikamente auf. Damit sind sie längst kein Thema mehr nur für Krankenhäuser: Auch private Haushalte, Büros, Werkstätten oder Pflegeeinrichtungen können unbemerkt zur Brutstätte gefährlicher Erreger werden.